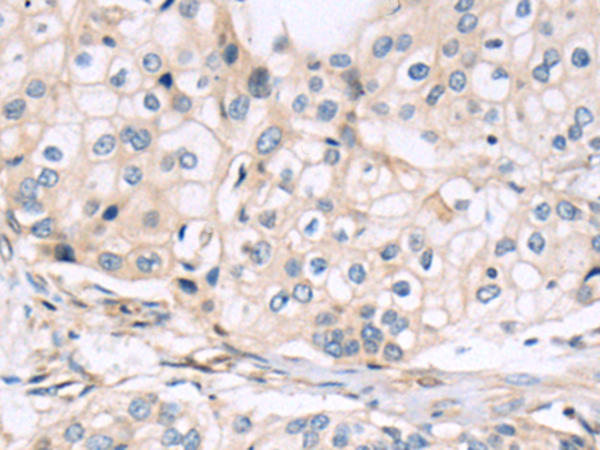

别名:xCT; CCBR1应用:WB,IHC
反应种属:Human, Mouse
规格:50μl/100μl
| Description |
|---|
| This gene encodes a member of a heteromeric, sodium-independent, anionic amino acid transport system that is highly specific for cysteine and glutamate. In this system, designated Xc(-), the anionic form of cysteine is transported in exchange for glutamate. This protein has been identified as the predominant mediator of Kaposi sarcoma-associated herpesvirus fusion and entry permissiveness into cells. Also, increased expression of this gene in primary gliomas (compared to normal brain tissue) was associated with increased glutamate secretion via the XCT channels, resulting in neuronal cell death. |
| Specification | |
|---|---|
| Aliases | xCT; CCBR1 |
| Swissprot | Q9UPY5 |
| WB Predicted band size | 55 kDa |
| Host/Isotype | Rabbit IgG |
| Storage | Store at 4°C short term. Aliquot and store at -20°C long term. Avoid freeze/thaw cycles. |
| Species Reactivity | Human, Mouse |
| Immunogen | Synthetic peptide of human SLC7A11 |
| Formulation | pH7.4 PBS, 0.05% NaN3, 40% Glycerol |
| Application | |
|---|---|
| WB | 1/1000-1/5000 |
| IHC | 1/50-1/100 |
| ELISA | 1/5000-1/10000 |
![]() |
Gel: 8%SDS-PAGE, Lysate: 40 μg, Lane 1-2: HepG2 and 293T cell lysates, Primary antibody: P12430(SLC7A11 Antibody) at dilution 1/1600, Secondary antibody: Goat anti rabbit IgG at 1/5000 dilution, Exposure time: 1 minute |
![]() |
The image is immunohistochemistry of paraffin-embedded Human?cervical?cancer tissue using P12430(SLC7A11 Antibody) at dilution 1/50. (Original magnification: ×200) |
本公司的所有产品仅用于科学研究或者工业应用等非医疗目的,不可用于人类或动物的临床诊断或治疗,非药用,非食用。
暂无评论
本公司的所有产品仅用于科学研究或者工业应用等非医疗目的,不可用于人类或动物的临床诊断或治疗,非药用,非食用。
中文

发表回复